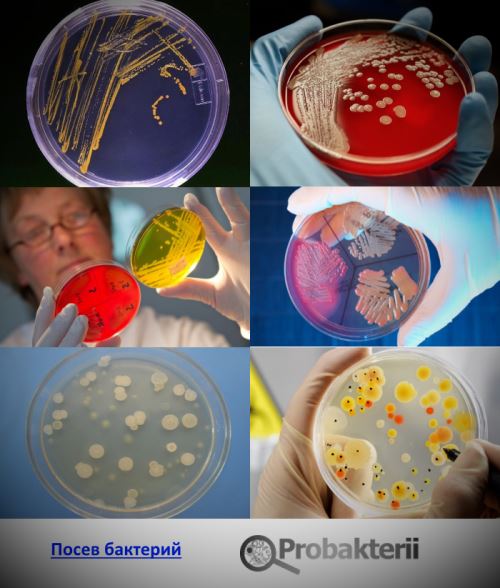
ed0dd8c7e195cc96b7c81b18db694b5e.png

Газовая гангрена развивается при инфицировании клостридиями обширных размозженных ран (огнестрельных, рвано-ушибленных), чаще нижних конечностей и туловища, ранениях толстого кишечника. Бактерии проникают в поврежденные ткани с землей, пылью, через обрывки одежды, осколки снарядов, при оперативных вмешательствах, инъекциях лекарственных препаратов, внебольничных абортах. При шахтных и транспортных травмах ранения чаще возникают в области ягодиц и бедер. Подвержены заболеванию лица, травмированные крупным рогатым скотом, свиньями, овцами и козами. Раны при этом загрязняются навозом животных. В некоторых случаях заболевание развивается при небольших, но загрязненных порезах. Заболевание развивается быстро. Первые его признаки появляются уже с первых суток травмирования.
к содержанию
Клостридии
Клостридии факультативные анаэробы (бактерии растут и размножаются при отсутствии доступа кислорода). Являются сапрофитами. Освобождают природу от мертвого органического материала через процессы брожения и гниения. Они присутствуют в кишечнике животных и человека, где питаются органическими остатками, но не инвазируют (проникают) в живые здоровые ткани.
Клостридии это бактерии палочковидной формы (бациллы), продуцирующие целый ряд токсинов и ферментов, образующие при неблагоприятных условиях споры. Патогенные формы возбудителей вызывают такие грозные заболевания, как столбняк, ботулизм и газовую гангрену. Они вырабатывают самые сильные из известных ядов тетаноспазмин (Clostridium tetani), ботулотоксин (Clostridium botulinum) и а-токсин (Clostridium perfringens).
Газовая гангрена практически всегда является смешанной инфекцией. Часто при инфицировании к клостридиям присоединяются аэробные микроорганизмы: стрептококки, стафилококки, кишечная палочка, протей и др.
Врачи подчеркивают, что возбудителем газовой гангрены является бактерия Clostridium perfringens, которая активно размножается в анаэробных условиях. Эта бактерия может попасть в организм через раны, особенно глубокие и загрязненные. Специалисты отмечают, что симптомы заболевания развиваются стремительно, включая сильную боль, отек и образование пузырей с газом. Важно, что при отсутствии своевременного лечения, которое может включать хирургическое вмешательство и антибиотикотерапию, заболевание может привести к серьезным осложнениям и даже летальному исходу. Врачи настоятельно рекомендуют обращать внимание на любые признаки инфекции после травм, особенно в условиях, где существует риск загрязнения. Профилактика, включая своевременную обработку ран и вакцинацию, играет ключевую роль в снижении заболеваемости.

Таксономия клостридий
Возбудители газовой гангрены относятся к семейству Bacillaceae, роду Clostridium. К роду Clostridium относятся многочисленные (около 80) видов клостридий.
Спорообразование клостридий
Клостридии при неблагоприятных условиях образуют споры, расположенные центрально или субтерминально. При центральном расположении спор палочка становится похожей на веретено (closter веретено).
Споры клостридий устойчивы к высушиванию, высокой температуре и солнечному свету. Они способны выживать в солевых растворах, переносить длительное кипячение, промораживание, ультрафиолетовое облучение, радиацию и вакуум. Споры проявляют устойчивость к целому ряду токсических и дезинфицирующих веществ.
В спорообразном состоянии бактерии могут находиться сотни лет. При благоприятных условиях внешней среды споры прорастают. Процесс прорастания длится 4 5 часов.
Возбудитель газовой гангрены, Clostridium perfringens, вызывает множество обсуждений среди медицинских специалистов и пациентов. Многие отмечают его опасность, особенно в условиях травм и хирургических вмешательств. Люди часто делятся историями о том, как быстро развиваются симптомы, включая сильную боль и отек, что подчеркивает необходимость срочной медицинской помощи. Врачебные сообщества акцентируют внимание на важности профилактики, особенно в условиях, где риск заражения высок. Некоторые пациенты, пережившие это заболевание, рассказывают о своем опыте лечения и реабилитации, подчеркивая значимость ранней диагностики и адекватной терапии. Обсуждения также касаются методов борьбы с инфекцией, включая использование антибиотиков и хирургическое вмешательство. В целом, тема газовой гангрены вызывает серьезные опасения и требует внимательного подхода как со стороны медиков, так и со стороны пациентов.

Морфология
Возбудитель газовой гангрены грамположительная палочка. Бактерии обычно подвижны, имеют капсулу. некоторые виды клостридий лишены капсулы, но имеют жгутики. Самая большая по размеру из всех клостридий является С. novyi. Все остальные бактерии значительно меньших размеров.
Биохимические свойства и токсины клостридий
Возбудители газовой гангрены ферментируют углеводы с образованием газа и кислоты, образуют сложные экзотоксины 12 ферментов (токсинов) и энтеротоксин, вызывающий воспаление кишечника. Бактерии делятся на шесть сероваров (А, В, С, D, E, F), каждый из которых имеет свои некротические характеристики. Серовар А является основным возбудителем газовой гангрены. Он формирует до 90% всех случаев заболевания. Основные мишени для токсинов являются мембраны клеток. Ферменты способствуют их расщеплению с последующим за этим отеком и аутолизом (саморастворением).
Бактерии типов А и С выделяют энтеротоксины, являющихся причиной пищевых токсикоинфекций и некротического энтерита.

Clostridium perfringens основной возбудитель газовой гангрены
Газовую гангрену, пищевые токсикоинфекции и некротический энтерит у человека и животных вызывают Clostridium perfringens типов А, С и D. Аналогичные заболевания, но только у животных вызывают Clostridium perfringens типов В, С, D и Е.
Возбудитель впервые был открыт Уэлчем и Нетталом в 1892 году.
Морфология Clostridium perfringens
Бактерии имеют вид палочек с закругленными концами. Они крупные, имеют размер 3-9 0,9-1,2 мкм. Неподвижные. Располагаются поодиночке. Выделенные из чистых культур клостридии имеют капсулу. Окрашиваются по Граму в фиолетовый цвет. Старые культуры утрачивают эту способность. Образуют споры, сохраняющие в окружающей среде многие десятилетия.
Культивирование Clostridium perfringens
Clostridium perfringens являются строгими облигатными анаэробами, хемоорганогетеротрофами. Растут на простых питательных средах сахарно-кровяном агаре и среде Китта-Тароцци. Рост бактерий сопровождается газообразованием и снижением рН в кислую сторону.
- На сахарно-кровяном агаре бактерии образуют гладкие, блестящие, округлой формы (S-колонии), либо колонии сероватого цвета, плоские, шероховатые с зазубренными краями (R-колонии). Вокруг колоний образуется зона гемолиза. При контакте с воздухом колонии приобретают зеленоватую окраску. Колонии в толще агара приобретают чечевицеобразную форму.
- При росте в жидких средах (среда Китта-Тароцци) образуется помутнение с интенсивным газообразованием. В последующем среда просветляется и на дно выпадает беловатого цвета пластиноподобный осадок.
- При росте на желчном агаре образуются зоны преципитации.
- При росте на молоке уже через 4 часа отмечается его интенсивное сворачивание, а сгусток из-за газообразования приобретает дырчатую структуру и часто подпрыгивает вверх. Подобная реакция используется в лабораториях для проведения экспресс-диагностики.
- При росте на мясном бульоне бактерии образуют уксусную и масляную кислоты, а также большое количество таких газов, как H2S, NH3 и CО.
Биохимические свойства клостридий
Мощная ферментативная активность бактерий послужила присуждению им эпитета perfringens, что обозначает разламывающий, прорывающий. Благодаря интенсивному газообразованию происходит отек поврежденных тканей и разрывы питательных сред. Clostridium perfringens вырабатывают огромное число сахаролитических ферментов, сбраживающих глюкозу, лактозу, мальтозу и сахарозу с последующим образованием кислоты и газа. Они интенсивно створаживают молоко с последующим образованием губчатого крупноячеистого сгустка (штормовая реакция).
Бактерии разлагают желатин, яичный белок, свернувшуюся сыворотку и коллаген. Не разлагает казеин.
В ходе ацетобутиратного брожения Clostridium perfringens синтезируют масляную кислоту, восстанавливают нитраты в нитриты, образуют лецитиназу.
Токсинообразование
Бактерии Clostridium perfringens по спектру продуцируемых ими токсинов (ферментов) подразделяются на типы A, B, C, и Е. Газовая гангрена и пищевые токсикоинфекции чаще связаны с типом А, некротизирующий энтероколит с типом С. Понятие токсин объединяет около 12 идентифицированных сегодня токсинов (ферментов) и энтеротоксин. Выброс ферментов в области поврежденных тканей приводит к расщеплению сложных веществ и нарушению клеточной проницаемости, в результате чего клетки отекают и расплавляются.
Основные экзотоксины клостридий
- а-токсин (фосфолипаза С). Более интенсивно продуцируется клостридиями типа А. Является основным и самым мощным токсином. Фермент гидролизирует (расщепляет) фосфолипиды клеточных мембран, что приводит к разрушению (лизису) клеток. Оказывает дерматонекротическое и летальное действие, является главным фактором внутритканевой инвазии и внутрисосудистого гемолиза символа смертельной клостридиальной токсинемии. Обладает лецитиназной активностью.
- b-токсин (цитотоксин). В основном, продуцируется клостридиями типов В и С. Оказывает дерматонекротическое и летальное действие, не вызывает гемолиз. Является причиной развития некротического энтерита.
- Тета-токсин. Обладает гемолитическим и дерматонекротическим действием. Чувствителен к кислороду. Имеет схожесть с О-стрептолизином стрептококков.
- v-токсин (протеиназы). Нарушают реакции белкового синтеза путем расщепления нуклеиновых кислот.
- р-токсин (коллагеназа и желатиназа). Продуцируется клостридиями типов А, С и Е, а также некоторыми штаммами бактерий типа D. Ферменты расщепляют желатин и коллагеновые волокна соединительной ткани. Оказывают некротизирующее и летальное действие.
- Мю-токсин (гиалуронидаза). Является фактором проникновения клостридий. Ферменты расщепляют кислые мукополисахариды и гиалуроновую кислоту.
- Ню-токсин (ДНК-за). Разрушает клеточную ДНК.
- q-гемолизин. При участии комплемента разрушает мембраны эритроцитов.
- Фибринолизин. Растворяет волокна фибрина.
- Гемагглютинин. При его участии происходит реакция агглютинации эритроцитов.
- у-токсин (протеиназа). По своему действию напоминает фибринолизин. Не расщепляет нативный (природный) коллаген, но разрушает азоколл (денатурированный коллаген), казеин и желатин.
- Дельта -токсин (эластаза). Является протеолитическим ферментом. Расщепляет белки и пептиды.
- Сигма-токсин. Продуцируют клостридии типа В и С. Оказывает летальное действие, проявляет гемолитическую активность.
- Омега-токсин. Продуцируется, в основном, клостридиями типа С. Оказывает дерматонекротическое и летальное действие.
- Эпсилон -токсин. Продуцируется клостридиями типовВ и D, l-токсин клостридиями типа Е. Проявляют летальное и дерматонекротизирующее действие.
- у- и n-токсины. Биохимическая природа этих токсинов остается неизвестной.
- р-токсин. Является фактором проницаемости тканей.
Энтеротоксин возбудителя газовой гангрены
Энтеротоксин продуцируют клостридии типов А и С.
- Энтеротоксин Clostridium perfringens штамма А представляет собой термолабильный белок, выделяющийся в тонком кишечнике в процессе образования спор. При его воздействии капилляры расширяются, повышается их проницаемость, усиливается секреция воды, ионов натрия и хлора, повреждаются мембраны энтероцитов.
- Энтеропатогенность Clostridium perfringens типа С связана с b-токсином. Заболевание протекает по типу некротизирующего энтерита.
Clostridium novyi
Clostridium novyi являются одним из основных возбудителей газовой гангрены. В годы Великой Отечественной войны причиной газовой гангрены в 42% случаев были бактерии этого вида. Впервые выделили возбудитель и дали ему название Clostridium oedematiens Э. Сэген и М. В. Вейнберг в 1891 году. Позже более полно этот вид клостридий был описан американским бактериологом Ф. Нови, чьим именем в дальнейшем стали называть этот вид бактерий.
Культивирование
Clostridium novyi являются строгими анаэробами. Высокочувствительны к кислороду. Растут на простых средах: углеводных, казеиновых и мясопептонных.
- При росте на плотных средах через 48 часов образуются полупрозрачные, сочные колонии сероватого цвета. Края неровные. Поверхность зернистая. Клостридии типов А, В и С иногда образуют дочерние колонии. Колонии окружены зоной гемолиза. Клостридии типа D эритроциты не разрушают.
В глубине агара колонии напоминают комочки ваты или снежные хлопья, часто окрашенные в коричневый или желтый цвет.
- При росте на жидких средах образуется газ и помутнение питательной среды, на дно выпадает осадок. рН сдвигается в кислую сторону за счет образования H2S и органических кислот.
Морфология Clostridium novyi
Клостридии представляют собой палочки, крупные, иногда слегка изогнутые, размером 4 22 х 1,4 2 мкм, подвижные, имеют до 25 жгутиков, располагаются часто цепочками. Возбудитель, как и все клостридии, являются облигатными анаэробами. Капсулу не образуют. Окрашиваются по Граму в фиолетовый цвет (грамположительные). Старые культуры утрачивают эту способность. Образуют овальной формы споры, располагающиеся центрально и субтерминально.
Антигенная структура
Clostridium novyi идентифицируются по выявлению соматических антигенов. Существует 4 серовара, различные по антигенным характеристикам и синтезируемых токсинов серовары А, В, С и D.
Биохимические свойства
Серовары типов А, В и С ферментируют фруктозу, глюкозу и мальтозу, серовары типа D ферментируют только глюкозу. Серовары типов А, С и D разлагают глицерин. Все штаммы свертывают молоко и разлагают желатин. Клостридии типа D образуют сероводород и индол, остальные типы бактерий нет.
Токсины Clostridium novyi
Clostridium novyi продуцируют такой фермент патогенности, как фосфолипазу (а-токсин), а также b, у, сигма, е и n токсины, обладающие некротическим, гемолитическим и летальным действиями. Нарушая проницаемость сосудов, они приводят к развитию желеобразного отека.
к содержанию
Clostridium septicum
Clostridium septicum впервые были описаны в 1877 году Л. Пастером. Эти бактерии являются условно-патогенными. В обычных условиях они пребывают в кишечнике человека и не вызывают заболевание. В случае дефектов кишечника, например при колоректальном раке, инфекция повреждает кишечник и с кровью (гематогенным путем) распространяется по организму. В отличие от Clostridium perfringens газовая гангрена может возникнуть без предварительных травм и повреждений. Инфекция чаще встречается у людей с травмами и ожогами кожи, после хирургических вмешательств и септических абортах, заболеваниях периферических сосудов, сахарном диабете, раке толстой кишки.
Заболевание развивается быстро. До 80% взрослых погибает в течение первых 2-х суток. Выживаемость повышается у лиц без сопутствующих заболеваниях нижних конечностей.
Clostridium septicum поражают как человека, так и домашних животных: крупный и мелкий рогатый скот.
Clostridium septicum представляет собой бактерию палочковидной формы. с размерами 3 4 х 1,1 1,6 мкм. В культурах иногда образуются нитевидные формы бактерий, имеющие в длину до 50 мкм в длину. Подвижны (имеют жгутики). Капсулу не образуют. Грамположительны. Со временем клостридии теряют эту особенность. Являются строгими анаэробами.
Clostridium septicum образуют споры. Споры чаще всего располагаются субтерминально, реже центрально.
Культуральные свойства
Clostridium septicum хорошо растут на казеиновых и мясных средах с добавлением глюкозы.
- На поверхности глюкозокровяного агара бактерии образуют полупрозрачные колонии, блестящие, состоящие из переплетающихся нитей с зоной гемолиза по периферии.
- При росте на 2% агаре колонии имеет вид дисков.
- При росте на агаре Цейсслера по истечении 48 часов образуется сплошной нежный налет с зоной гемолиза по периферии.
- При росте в 1% сахарном агаре колонии образуются в глубине. У них уплотненный центр, от периферии отходят переплетающиеся нити.
- При росте на мясопептонном бульоне образуется равномерное помутнение. Далее отмечается выпадение рыхлого осадка и газообразование.
- При росте на среде Китта-Тароцци бактерии растут с интенсивным газообразованием.
Clostridium septicum имеют Н и О антигены. По антигенам Н определяется 6 сероваров: А, В, С, D, E и F.
Clostridium septicum синтезируют ряд ферментов. Они живут на различных органических субстратах, в том числе содержащих сахара и аминокислоты с выделением углекислого газа и молекулярного водорода.
Бактерии ферментируют некоторые углеводы: глюкозу, мальтозу и лактозу с образованием газа и кислоты. Нитраты переводят в нитриты. Расщепляют белки с выделением аммиака и сероводорода. Молоко под действием бактерий свертывается медленно. Не разлагают сахарозу, глицерин и маннит. Не образуют индол.
Патогенность
C. perfringens является возбудителем пищевых отравлений человека и одним из возбудителей газовой гангрены. Синтезируют протеиназы, лецитиназу, коллагеназу, гиалуронидазу и другие ферменты агрессивности. Продуцируют также токсины[11] [12] [13]. -токсин является фосфолипазой С, обладающей гемолитическими свойствами[14], -токсин является белком размером 300 аминокислот, образующий поры в мембранах эпителиоцитов кишечника человека и вызывающий выход ионов K+ и воды из клетки, LD50 для мышей составляет 0,1 мкг на кг веса[15].
Крупные (0,81,5 48 мкм) полиморфные палочковидные грамположительные бактерии. Споры овальные, расположены центрально либо субтерминально. Неподвижны, в организме человека образуют капсулу. Образуют стабильные L-формы, способные расти на поверхности стекла[1].
Общие характеристики
Эта бактерия приобретает характерную пурпурную тональность, когда подвергается процессу окрашивания по Граму. Из-за этого это считается грамположительным.
Это связано с толстым слоем peptidiglicano, который находится в его клеточной стенке. Улавливает частицы граммового красителя и удерживает его.
Производит споры
Бактериальные клетки Clostridium perfringens они производят одну спору, которая находится на одном из его концевых концов. В процессе образования спор синтезируются токсины, которые смертельны для человека и широкого круга животных..
среда обитания
Это бактерия, которую можно найти в большом количестве сред. Это часть нормальной флоры желудочно-кишечного тракта, а также в коже. Он также распространяется в почве, загрязненной воде и пыли.
Вырабатывает энтеротоксин
Clostridium perfringens Он производит несколько токсинов. Среди них наиболее известны:
- Энтеротоксин: основная причина пищевых отравлений.
- Альфа-токсин: обычно участвует в газовой гангрене у людей, а также при некротическом энтерите кур, крупного рогатого скота и лошадей.
- Токсин бета: согласно различным исследованиям, этот токсин может действовать как нейротоксин и вызывать артериальное сужение. Это также связано с определенными патологиями желудочно-кишечного тракта у некоторых млекопитающих.
- Токсин Эпсилон: это один из самых смертельных токсинов, вырабатываемых любой бактерией рода, его биологическая активность выражается в отеке. Это также dermonecrotic. Аналогичным образом, согласно различным исследованиям, было показано, что он способен преодолевать гематоэнцефалический барьер, который обеспечивает доступ к мозгу и накапливается в нем..
- Йота-токсин: это дермонекротический токсин, который вызывает повреждение на желудочно-кишечном уровне. Это также энтеротоксический и цитотоксический.
Это строгий анаэроб
Эта бактерия является строго анаэробным организмом, это означает, что ей не нужен кислород для осуществления своих метаболических процессов. Несмотря на это, кислород не токсичен, так как он может выживать в средах с низким расположением этого элемента.
Лечение
Медикаментозное лечение клостридиоза предусматривает использование таких препаратов:
- Метронидазол.
- Ванкомицин.
- Фидаксомицин.
Также при необходимости назначают другие препараты:
- При введении Метронидазола внутривенно могут назначаться энтеросорбенты ( активированный уголь, Энтеросгель и др.). Их также применяют при легких формах болезни. При пероральном применении антибиотиков энтеросорбенты не назначают, чтобы не уменьшить эффективность антибактериальной терапии.
- Если отравление произошло вследствие заражения CL perfringens, проводится лечение антибиотиками широкого спектра действия. Больным назначают Левомицетин, Тетрациклин, Эритромицин.
- Если существуют показания, назначают инфузионное лечение для дезинтоксикации, нормализации водно-электролитного баланса. Возможно проведение парентерального питания.
- После проведения антибактериального лечения с целью санации кишечника назначают прием пробиотиков это Лактобактерин, Линекс, Хилак Форте.
- Показано применение ферментных препаратов Креон, Фестал и др.
- Рекомендуется прием витаминов, в частности группы В.
Процедуры и операции
Если произошло отравление, с целью удаления токсинов как можно раньше промывают желудок водой или 5% раствором натрия гидрокарбоната.
Лечение предусматривает соблюдение диеты тип питания должен быть щадящим. Важно также придерживаться общих рекомендаций: соблюдать личную гигиену, свести к минимуму контакты с домашними животными.
Лечение народными средствами
Применять народные методы можно только в том случае, если человек уже восстанавливается после перенесенной болезни. Перед этим следует посоветоваться с лечащим врачом. В восстановительный период можно готовить следующие средства:
Такие напитки нужно принимать на протяжении 2 недель. Можно чередовать их прием, готовя каждый день новое средство.
Профилактика
Чтобы избежать клостридиоза, необходимо придерживаться следующих мер профилактики:
- Не принимать антибиотики широкого спектра действия без назначения врача, особенно продолжительными курсами. Особенно сильно возрастает риск клостридиоза при применении ампициллина и аминогликозидов (энтеральные формы).
- Важно соблюдать правила гигиены.
- Необходимо правильно обрабатывать термически пищу, не употреблять испорченных и просроченных продуктов, консервов.
У детей
В норме показатель клостридии у ребенка до года в кале равен от 102 до 103 КОЕ/г. У подростков эти показатели в норме равны 103-105 КОЕ/г. Если клостридии в кале у ребенка определяются в больших количествах, и при этом есть другие нарушения микрофлоры кишечника, необходимо обязательно провести адекватную терапию. Особенно важно своевременно принять меры, если повышены клостридии в кале у грудничка.
Диета
Если взрослый или ребенок проходит курс терапии от болезни, спровоцированной клостридиями, он должен обязательно придерживаться специальной диеты.
Важно исключить из рациона такие продукты:
- Те, что воздействуют послабляюще: бобовые, капуста, свекла, курага, чернослив и др.
- Любую консервацию.
- Маринованную и острую пищу.
- Фастфуд, любые колбасные изделия.
- Грибы, лук, чеснок, редис, редьку.
- Жареную, жирную пищу.
- Сладости, газировку.
- Алкогольные напитки.
В меню нужно обязательно ввести следующие продукты и блюда:
- Те, что обладают скрепляющим действием: отвар изюма, рис, бананы и др.
- Продукты с молочнокислыми бактериями: йогурт, кефир.
Рацион можно составлять из таких продуктов:
- Мясо и рыба постных сортов.
- Отварные и запеченные овощи, зелень.
- Некислые ягоды и фрукты.
- Яйца.
- Крупы.
- Растительные масла.
Есть нужно небольшими порциями и часто. Стоит избегать слишком горячих и очень холодных блюд.
Последствия и осложнения
Слишком активное размножение клостридий в организме способно спровоцировать развитие тяжелых заболеваний, которые, при отсутствии адекватной терапии, могут привести к летальному исходу. Поэтому очень важно своевременно диагностировать такие заболевания и провести их лечение.
Прогноз
Прогноз зависит от тяжести поражения и правильности лечения.
Клостридиозы у животных
К наиболее опасным клостридиозам крупного рогатого скота и других сельскохозяйственных животных относятся:
- столбняк (Clostridium tetani);
- ботулизм (Cl. botulinum);
- эмфизематозный карбункул (Cl. chauvoei);
- злокачественный отек (Cl. septicum, Cl.novyi, Cl. perfringens).
Так как перечисленные клостридиозы имеют большой процент смертности среди КРС, МРС, свиней и лошадей, а также несут угрозу жизни человека, то большое внимание уделяется профилактическим мероприятиям и недопущению заноса возбудителя в хозяйство с зараженными кормами или инфицированными животными. В мире уделяется огромное внимание лечению клостридиозов у животных, ведь от этого зависит здоровье людей
В мире уделяется огромное внимание лечению клостридиозов у животных, ведь от этого зависит здоровье людей
Вакцинацию телят от эмкара в хозяйстве, где ранее регистрировался клостридиоз, проводят в возрасте от 1,5 до 4 месяцев.
Стельным коровам вводят вакцину Комбовак для КРС против вирусных заболеваний, которые резко снижают иммунитет и повышают риск заражения клостридиозами. Телята получают антитела с молоком матери.
Разработана специальная вакцина против клостридиоза КРС и овец Клостбовак-8, применяемая с 45-дневного возраста, обеспечивающая иммунитет вакцинированных животных на протяжении 12 месяцев после двукратного введения. Препарат не применяется для лечения.
Для лечения при клостридиозах коров используют гипериммунные сыворотки, специфические анатоксины, антибиотики, симптоматические препараты.
К клостридиозами овец относится брадзот, возбудителем которого становится Cl. septicum. Преимущественно болезнь протекает в молниеносной форме. Чаще заражаются упитанные продуктивные животные при поедании недоброкачественных кормов или фекалий зараженных особей. Гибель наступает в течение 20-30 минут ночью или во время выгона пастбище. При затяжном течении брадзота назначают антибиотики.
К клостридиозам овец также относится анаэробная дизентерия ягнят, провоцируемая Clostridium perfringens типа В. Проявляется сильной диареей с примесью крови, токсемией и гибелью в течение первых суток после рождения.
К клостридиозам свиней относится анаэробная энтеротоксемия, характеризующаяся поражением эпителия ЖКТ, диареей, рвотой, другими явлениями интоксикации. Данный клостридиоз отличается высоким коэффициентом летальности, особенно у поросят.
Клостридии представляют опасность для фермерского скота
Клостридиозом птиц, снижающим продуктивность и приводящим к гибели 1% поголовья в день, считается некротический энтерит. Так как лечение у кур полностью не восстанавливает функции кишечника, то ветеринарные специалисты прикладывают значительные усилия, чтобы не допустить появления клостридиоза в хозяйстве.
Лабораторная диагностика
Диагностика клостридиозов основывается на анамнестических данных и клинических симптомах. Также подробно выясняется, какую пищу пациент употреблял в последнее время, проходил ли курс антибиотикотерапии, получал ли травмы. Окончательный диагноз ставится только после проведения лабораторных исследований:
- Бактериоскопия соскобов и мазков-отпечатков первичного материала.
- Идентификация возбудителя путем посева патологического материала на питательные среды.
- Выявление патогенности микробов с помощью биопробы.
- Инструментальная диагностика.
В кале обнаруживается небольшое количество бактерий, и это норма
Обнаружение клостридий в кале у ребенка не является подтверждением диагноза, так как они входят в состав нормальной кишечной микрофлоры. Но их количество не должно превышать:
- 103 104 КОЕ/г у детей первого года жизни;
- 105 КОЕ/г от 1 года до 16 лет;
- 106 КОЕ/г старше 16 лет.
Диагноз подтверждается, если при анализе кала обнаруживается:
Но некоторые патогенные клостридии в кале не имеют диагностического значения, так как, находясь в кишечнике, не могут вырабатывать токсины, вызывающие заболевание. К таким микробам относится Cl.tetani, палочки которой могут оказаться в каловых массах случайно.
Для идентификации клостридий используются посевы на питательные среды. После начала роста колоний учитывается их цвет, форма, ровность краев, способность к гемолизу и газообразованию.
Биоматериал от заболевших или павших сельскохозяйственных животных исследуют согласно стандартам ГОСТ26503-85.
В пищевых продуктах количество и видовая принадлежность сульфитредуцирующих клостридий определяют по методикам, указанным в ГОСТ 29185-91. Наибольшую опасность для человека представляют мясные, рыбные и овощные консервы, в которых созданы анаэробные условия.
Лечение недуга
Изменение объема клостридий в кале зависит от множества факторов. Это и стрессы, и нервные расстройства, и неправильное питание, а также многое другое.
- высокая температура (от 39,5);
- снижение аппетита;
- резкое похудение;
- рвота;
- вздутие живота;
- интоксикация;
- наличие в кале крови, слизи, фиброзных наложений;
- боли схваткообразного характера в животе;
- водянистый стул с зеленоватым оттенком и гнилостным запахом.
Лечением заболеваний, которые вызываются различными типами клостридий занимаются врачи-инфекционисты, гастроэнтерологи или врачи семейной практики. Зачастую лечение заключается в особой терапии. Для начала врач исключает прием антибактериальных препаратов и назначает средства, способствующие восстановлению естественной микрофлоры кишечника. В качестве средств, применяемых для этих целей, выделяют Лактобактерин, Линекс, Бификол, Хилак-форте, Бифидумбактерин и другие.
Кроме того, для понижения объема клостридий назначают Метронидазол и Ванкомицин, поскольку данные организмы имеют к ним повышенную чувствительность. При тяжелом течении и развития заболевания также проводят инфузионную терапию, которая заключается в восстановлении организмом потерянного объема жидкости. Зачастую курс лечения заболеваний, вызванных увеличением объема клостридий, заключается в приеме эубиотиков, витамина В, препаратов, содержащих специальные ферменты и энтеросорбентов.
Как и в случае с любыми заболеваниями такого типа их проще предотвратить, чем лечить, поэтому важно соблюдать меры профилактики. Они заключаются в соблюдении санитарно-гигиенических норм, которые касаются приготовления пищи, гигиены рук и продуктов питания
Все овощи и фрукты перед употреблением желательно не просто мыть в проточной воде, а ошпаривать кипятком
А также важно следить за общим состоянием микрофлоры кишечника и поддерживать работу иммунной системы. Антибиотики для лечения стоит использовать только по назначению врача, а после их приема желательно пройти курс терапии, способствующей восстановлению микрофлоры кишечника
Вопрос-ответ
Кто возбудитель газовой гангрены?
Clostridium perfringens (90 % случаев)
Какой микроорганизм вызывает газовую гангрену?
Газовая гангрена обычно поражает глубокие мышцы, обычно ее вызывают бактерии Clostridium perfringens, которые размножаются в местах травмы или хирургической раны, обедненных кровоснабжением.
Что может вызвать гангрену?
Причиной гангрены могут быть отморожения, ожоги, травмы, инфекция, но чаще всего она возникает при недостаточном кровоснабжении органа (подобное состояние называется ишемией). Наиболее часто кровообращение нарушается в нижних конечностях и приводит к омертвению пальцев, стопы или всей ноги.
Какой путь передачи газовой гангрены?
Газовая гангрена – это очень тяжелый инфекционный процесс, который развивается в результате инфицирования ран анаэробными бактериями, обитающими в земле и уличной пыли.
Советы
СОВЕТ №1
Изучите симптомы газовой гангрены, такие как сильная боль, отек, изменение цвета кожи и выделение газа. Это поможет вам быстро распознать заболевание и обратиться за медицинской помощью.
СОВЕТ №2
Обратите внимание на профилактику: следите за чистотой ран и травм, особенно в условиях, где есть риск заражения. Используйте антисептики и своевременно обрабатывайте повреждения кожи.
СОВЕТ №3
Если у вас есть хронические заболевания или ослабленный иммунитет, регулярно проходите медицинские осмотры и обсуждайте с врачом меры по профилактике инфекций, включая газовую гангрену.
СОВЕТ №4
При наличии подозрений на газовую гангрену не откладывайте визит к врачу. Быстрая диагностика и лечение критически важны для успешного исхода и минимизации осложнений.